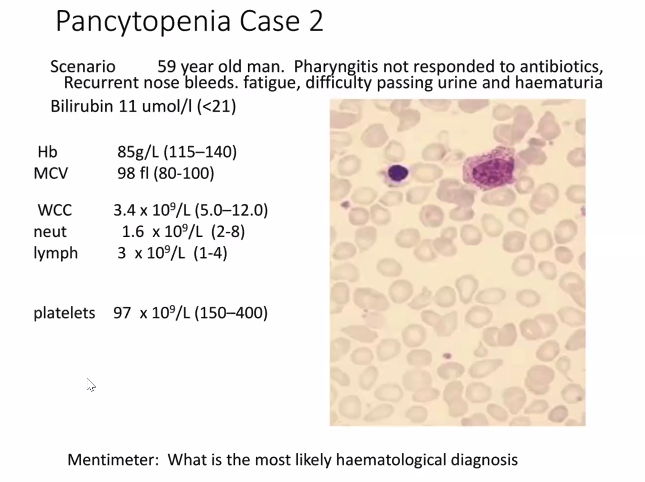

How should you interpret an FBC?

What are the common features of haemolytic anaemias?

What is the difference between inherited and acquired haemolytic anaemias?

Give examples of inherited and acquired haemolytic anaemias.
- MAHA
- Drug-induced
- HUS
- Infections: malaria
- Aortic stenosis


- 3 most likely causes of this anaemia (low MCV anaemia):
- Iron deficiency
- Thalassaemia
- Anaemic of chronic disease (normal or low MCV)
How do you differentiate between anaemia of chronic disease and iron deficiency anaemia?

What happens during anaemia of chronic disease?

What causes an isolated single lineage cytopenia with otherwise normal FBC?


B12 deficiency - super high MCV (only seen due to folate and B12 deficiency)
Likely has autoimmune disorder of parietal cells
Leukoerythroblastic anaemia - marrow cells being forced out due to infiltrative cancer
Could be due to blood cancer or a metastatic non-haematological cancer (likely prostate due to difficulty urinating)

BCR ABL1 - PCR Assay
What is the hx, exam, FBC and Blood film finding in CML?


Tyrosine kinase inhibitor (acts predominantly on ABL)

Blast crisis

JAK2V617F mutation analysis

CLL - Immunophenotyping for CD19/CD5/CD3 expression

Target malignant B cells with Ibrutinib
Ruxolotinib - polycthaemia vera

Multiple myeloma
What are the clinical features of myeloma?

What is the likely cause of renal failure in MM?
Cast nephropathy (free light chains can pass the glomeruli and cause failure)


